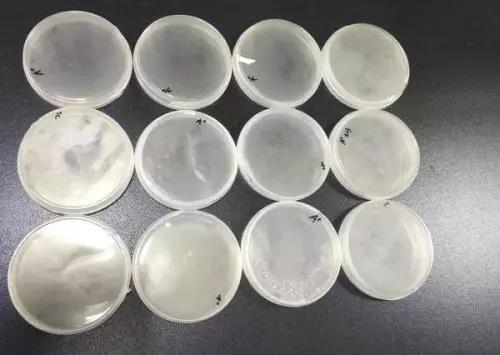

微生物實驗容易被污染,所以,對實驗環境、設備和人員都需要很高的要求。在實驗過程中需要注意的事項也很多,小析姐就其中的幾點和大家進行學習。

無菌操作要求
1. 接種細菌時必須穿工作服、戴工作帽。
2. 進行接種食品樣品時,必須穿專用的工作服、帽及拖鞋,應放在無菌室緩沖間, 工作前經紫外線消毒后使用。
3. 接種食品樣品時,應在進無菌室前用肥皂洗手,然后用75%酒精棉球將手擦干凈。
4. 進行接種所用的吸管,平皿及培養基等必須經消毒滅菌,打開包裝未使用完的器皿,不能放置后再使用,金屬用具應高壓滅菌或用95%酒精點燃燒灼三次后使用。
5. 從包裝中取出吸管時,吸管尖部不能觸及外露部位,使用吸管接種于試管或平皿時,吸管尖不得觸及試管或平皿邊。
6. 接種樣品、轉種細菌必須在酒精燈前操作,接種細菌或樣品時,吸管從包裝中取出后及打開試管塞都要通過火焰消毒。
7. 接種環和針在接種細菌前應經火焰燒灼全部金屬絲,必要時還要燒到環和針與桿的連接處,接種結核菌和烈性菌的接種環應在沸水中煮沸5min,再經火焰燒灼。
8. 吸管吸取菌液或樣品時,應用相應的橡皮頭吸取,不得直接用口吸。

不同型號的接種針和接種環
無菌間使用要求
1、無菌間通向外面的窗戶應為雙層玻璃,并要密封,不得隨意打開,并設有與無菌間大小相應的緩沖間及推拉門,另設有0.5-0.7平方米的小窗,以備進入無菌間后傳遞物品。
2、無菌間內應保持清潔,工作后用2%-3%煤酚皂溶液消毒,擦拭工作臺面,不得存放與實驗無關的物品。
3、無菌間使用前后應將門關緊, 打開紫外燈,如采用室內懸吊紫外燈消毒時,需30W紫外燈,距離在1.0m處,照射時間不少于30min,使用紫外燈,應注意不得直接在紫外線下操作,以免引起損傷,燈管每隔兩周需用酒精棉球輕輕擦拭,除去上面灰塵和油垢,以減少紫外線穿透的影響。
4、處理和接種食品標本時,進入無菌間操作,不得隨意出入,如需要傳遞物品,可通過小窗傳遞。
5、在無菌間內如需要安裝空調時,則應有過濾裝置。

消毒滅菌要求
微生物檢測用的玻璃器皿、金屬用具及培養基、被污染和接種的培養物等,必須經滅菌后方能使用。滅菌方式有干熱和濕熱高壓蒸氣鍋滅菌方法和間歇滅菌方法
1、滅菌前準備
(1)所有需要滅菌的物品首先應清洗晾干,玻璃器皿如吸管、平皿用紙包裝嚴密,如用金屬筒應將上面通氣孔打開。
(2)裝培養基的三角瓶塞,用紙包好,試管蓋好蓋,注射器須將管芯抽出,用紗布包好。
2、裝放
(1)干熱滅菌器:裝放物品不可過擠,且不能接觸箱的四壁。
(2)大型高壓蒸氣鍋::放置滅菌物品分別包扎好,直接放入消毒筒內,物品之間不能 過擠。
3、設備檢查
(1)檢查門的開關是否靈活,橡皮圈有無損壞,是否平整。
(2)檢查壓力表蒸氣排盡時是否停留在零位,關好門和蓋,通蒸氣或加熱后,觀察是式高壓鍋或立式壓力蒸氣滅菌器的使用應按下列步驟進行:
①手提式高壓鍋在主體內加入3L清水,立式高壓鍋加水16L(重復使用時應將水 量補足,水變混濁需更換).
②手提式壓力鍋將頂蓋上的排氣管插入消毒桶內壁的方管中(無軟管或軟管銹蝕破裂的滅菌器不得使用)。
③蓋好頂蓋擰緊,勿使漏氣;置滅菌器于火源上加熱,立式壓力鍋通上電源,并打開頂蓋上的排氣閥放了冷氣(水沸騰后排氣10-15min)。
④關閉排氣閥,使蒸氣壓上升到規定要求,并維持規定時間(按滅菌物品性質與有關情況而定)。
⑤達到規定時間后,對需干燥的物品,立即打開排氣閥排出蒸氣,待壓力恢復到零時,自然冷卻至 60℃后開蓋取物,如為液體物品,不要打開排氣閥,而應立即將鍋去除熱源,待自然冷卻,壓力恢復至零,溫度降到60℃以下再開蓋取物,以防突然減壓液體劇烈沸騰或容器爆破。
(3)臥式壓力鍋蒸氣滅菌器的使用按下列步驟進行:
①關緊鍋門,打開進氣閥,將蒸氣引入夾層進行預熱,夾層內冷空氣經阻氣器自動排出。
② 夾層達到預定溫度后,打開鍋室進氣閥,將蒸氣引入鍋室,鍋室內冷空氣經鍋室阻氣器自動排出。
③待鍋室達到規定的壓力與溫度時,調節進氣閥,使保持恒定。
④自然或人工降溫至60℃再開門取物,不得使用快速排出蒸氣法,以防突然降壓,液體劇烈沸騰或容器爆破。
⑤使用自動程序控制式壓力蒸氣滅菌器,在放好物品關緊門后,應根據物品類別按 動相應開關,以便按要求程序自動進行滅菌,滅菌時必須利用附設儀表記錄溫度與時間以備查,操作要求應嚴格按照廠家說明書進行。
4、滅菌溫度與時間
壓力蒸氣滅菌鍋滅菌溫度與時間見下表:

?(1)干熱滅菌器滅菌溫度160℃,1.5-2h。
(2)壓力蒸氣滅菌 鍋滅菌溫度與時間。

間接滅菌方法
1、滅菌方法系利用不加壓力的蒸氣滅菌,某些物質經高壓蒸氣滅菌容易破壞,可用此法滅菌。
(1)將欲滅菌物品置于鍋內,蓋上頂蓋,打開排水口,使器內余水排盡。
(2)關閉排水口,打開進氣門,根據需要消毒10~20min。
(3)滅菌完畢關閉進氣門,取出物品待冷至室溫溫度,放入37℃溫箱過夜,次日仍按上述方法消毒,如此三次,即可達到滅菌目的。
2、煮沸消毒:可用煮鍋或煮沸消毒器,水沸騰后再煮5~15 min,也可在水中加入2%石炭酸煮沸5 min,加入0.02%甲醛,80℃煮60 min均可達到滅菌目的, 但選用 煮沸消毒的增消劑時, 應注意對物品的腐蝕性。
滅菌后處理
滅菌后物品,按正常情況已屬無菌,從滅菌器中取出應仔細檢查放置,以免再度污染。
1.物品取出,隨即檢查包裝的完整性,若有破壞或棉塞脫掉,不可作為無菌物品使用。
2.取出的物品,如為包裝有明顯的水浸者,不可作為無菌物品使用。
3.培養基或試劑等,應檢查是否符合達到滅菌后的色澤或狀態,未達到者應廢棄。
4.啟閉式容器,在取出時應將篩孔關閉。
5.取出的物品掉落在地或誤放不潔這處,或沾有水液,均視為受到污染,不可作為無菌物品使用。
6.取出的合格滅菌物品,應存放于貯藏室或防塵柜內,嚴禁與未滅菌物品混放。
7.凡屬合格物品,應標有滅菌日期及有效期限。
8.每批滅菌處理完成后,記錄滅菌品名、數量、溫度、時間、操作者。
有毒有菌污物處理要求
微生物實驗所用實驗器材、培養物等未經消毒處理,一律不得帶出實驗室。
1、經培養的污染材料及廢棄物應放在嚴密的容器或鐵絲筐內,并集中存放在指定地點,待統一進行高壓滅菌。
2、經微生物污染的培養物,必須經121℃30min高壓滅菌。
3、染菌后的吸管,使用后放入5%煤酚皂溶液或石炭酸液中,最少浸泡24h(消毒液體不得低于浸泡的高度)再經121℃30 min高壓滅菌。
4、涂片染色沖洗片的液體,一般可直接沖入下水道,烈性菌的沖洗液必須沖在燒杯 中,經高壓滅菌后方可倒入下水道,染色的玻片放入5%煤酚皂溶液中浸泡24h后,煮沸洗滌。做凝集試驗用的玻片或平皿,必須高壓滅菌后洗滌。
5、打碎的培養物,立即用5%煤酚皂溶液或石炭酸液噴灑和浸泡被污染部位,浸泡半小時后再擦拭干凈。
污染的工作服或進行烈性試驗所穿的工作服、帽、口罩等,應放入專用消毒袋內,經高壓滅菌后方能洗滌。
培養基制備要求
培養基制備的質量將直接影響微生物生長。因為各種微生物對其營養要求不完全相同,培養目的的不同,各種培養基制備要求如下:
1、根據培養基配方的成分按量稱取,然后溶于蒸餾水中,在使用前對應用的試劑藥品應進行質量檢驗。
2、PH 測定及調節:PH測定要在培養基冷至室溫時進行,因在熱或冷的情況下,其PH有一定差異,當測定好時,按計算量加入堿或酸混勻后,應再測試一次。培養基 PH值一定要準確,否則會影響微生物的生長或影響結果的觀察。但需注意因高壓滅菌可影響一些培養基的 PH 降低或升高,故不宜滅菌壓力過高或次數太多,以免影響培養基的質量,指示劑、去氧膽酸鈉、瓊脂等一般在調完PH后再加入。
3、培養基需保持澄清,便于觀察細菌的生長情況,培養基加熱煮沸后,可用脫脂棉 花或絨布過濾,以除去沉淀物,必要時可用雞蛋白澄清處理,所用瓊脂條要預先洗凈晾干后使用,避免因瓊脂含雜質而影響透明度。
4、盛裝培養基不宜用鐵、銅等容器,使用洗凈的中性硬質玻璃容器為好。
5、培養基的滅菌既要達到完全滅菌目的,又要注意不因加熱而降低其營養價值,一般121℃15min即可,如為含有不耐高熱物質的培養基如糖類、血清、明膠等,則應采用低溫滅菌或間歇法滅菌,一些不能加熱的試劑如亞碲酸鉀、卵黃、TTC、抗菌素等,待基礎瓊脂高壓滅菌后涼至50℃左右再加入。
6、每批培養基制備好后,應做無菌生長試驗及所檢菌株生長試驗。如果是生化培養 基,使用標準菌株接種培養,觀察生化反應結果,應呈正常反應,培養基不應貯存過久,必要時可置4℃冰箱存放。
7、目前各種干燥培養基較多,每批需用標準菌株進行生長試驗或生化反應觀察,各種培養基用相應菌株生長試驗良好后方可應用,新購進的或存放過久的干燥培養基,在配制時也應測PH,使用時需根據產品說明書用量和方法進行。
8、每批制備的培養基所用化學試劑、滅菌情況及菌株生長試驗結果、制作人員等應做好記錄,以備查詢。
樣品采集及處理要求
1、所采集的檢驗樣品一定要具有代表性,采樣時應首先對該批食品原料、加工、運輸、貯藏方法條件、周圍環境衛生狀況等進行詳細調查,檢查是否有污染源存在。
2、根據食品的種類及數量,采樣數量及方法應按標準檢驗方法的要求進行。
3、采樣應注意無菌操作,容器必須滅菌,避免環境中微生物污染,容器不得使用煤酚皂溶液,用新潔爾滅、酒精等消毒藥物滅菌,更不能含有此類消毒藥物或抗生素類藥物,以避免殺死樣品中的微生物,所用剪、刀、匙用具也需滅菌方可應用。
4、樣品采集后應立即送往檢驗室進行檢驗,送檢過程中一般不超過3h,如路程較遠,可保存在1~5℃環境中,如需冷凍者,則在凍存狀態下送檢。
5、檢驗室收到樣品后,進行登記(樣品名稱、送檢單位、數量、日期、編號等),觀察樣品的外觀,如果發現有下列情況之一者,可拒絕檢驗。
(1)樣品經過特殊高壓、煮沸或其他方法殺菌者,失去代表原食品檢驗意義者。
(2)瓶、袋裝食品已啟開者,熟肉及其制品、熟禽等食品已折碎不完整者,即失去原食品形狀者(食物中毒樣品除外)。
(3)按規定采樣數量不足者。
對送檢符合要求的樣品, 檢驗室收到后,應立即進行檢驗,如果條件不具備,應置4℃冰箱存放,及時準備創造條件,然后進行檢驗。
6、樣品檢驗時,根據其不同性狀,進行適當處理。
(1)液體樣品接種時,應充分混合均勻,按量吸取進行接種。
(2)固體樣品,用滅菌刀、剪取其不同部位共25g,置于225ml 滅菌生理鹽水或其他溶液中,用均質器攪碎混勻后,按量吸取接種。
(3)瓶、袋裝食品應用滅菌操作啟開,根據性狀選擇上述方法處理后接種。
記錄和報告的要求
1、檢驗室收到樣品后,首先進行外觀檢驗,及時按照國家標準檢驗方法進行檢驗, 檢驗過程中要認真、負責、嚴格進行無菌操作,避免環境中微生物污染。
2、樣品檢驗過程中所用方法、出現的現象和結果等均要用文字寫出試驗紀錄,以作為對結果分析、判定的依據,記錄要求詳細、清楚、真實、客觀、不得涂改和偽造。





